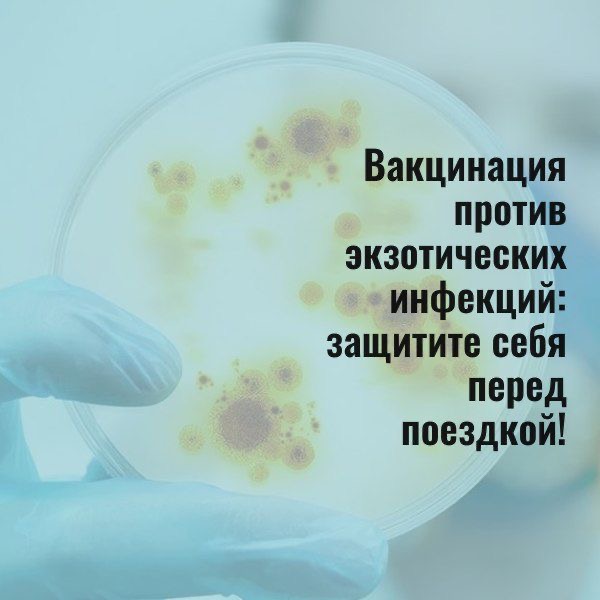

Прививки от экзотических инфекций — желтой лихорадки, лихорадки Ку, холеры, брюшного тифа – рекомендованы людям, выезжающим в неблагополучные по заболеванию регионы и работающим с поступающей оттуда продукцией.
Желтая лихорадка — острая инфекция с тяжелым течением, переносимая комарами — одно из самых распространенных заболеваний в странах Африки и Южной Америки. Для въезда в некоторые из них прививка является обязательной. Сделать ее нужно не позднее 10 дней до отъезда, после чего формируется пожизненный иммунитет.
Лихорадка Ку — легочный тиф — переносимая клещами, дикими и домашними животными и птицами инфекция — распространена по всему миру, в том числе и в российских регионах. Чаще всего случаи заболевания фиксируются в Америке и Австралии. Возбудители болезни — бактерии риккетсии — попадая в организм, внедряются и поражают печень, легкие, сосуды, суставы. Если лечение было начато не своевременно, заболевание может стать хроническим, с частыми рецидивами. Привиться от лихорадки Ку нужно за 3–4 недели до поездки.
Холера — инфекционная болезнь, протекающая с поражением желудочно-кишечного тракта, при отсутствии лечения из-за обезвоживания за несколько часов может привести к смерти. Вспышки заболеваемости регулярно фиксируются в странах Азии, Африки и Южной Америки. Пероральная вакцина применяется за 10–14 дней до посещения эндемичных районов.
Брюшной тиф — острая кишечная инфекция, широко распространенная в странах Азии, Африки и Индии. В мире ежегодно регистрируется более 20 млн случаев брюшного тифа, а смертность от этого заболевания достигает 4%. Прививку, которая обеспечит иммунитет на 3 года, необходимо сделать за 1–2 недели до поездки. Помимо путешественников, вакцинации подлежат работники, обслуживающие канализационное оборудование и осуществляющие транспортировку и утилизацию бытовых отходов.